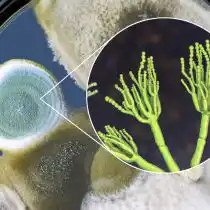
Пеницилл (Penicillium). Оказывает влияние на рост растений, обусловленное продукцией и секрецией гиббереллинов, которые стимулируют рост корней

7 типів ґрунтових мікроорганізмів для підтримки здоров'я рослин.

У багатьох з нас бактерії та грибки насамперед асоціюються з патогенами, які спричиняють хвороби рослин. Однак це не завжди так. Багато грунтових мікробів відіграють фундаментальну роль у нашому житті: живлять рослини, які ми вирощуємо для їжі і необхідні нам для життя на цій планеті. Давайте подивимося, які крихітні мікроорганізми особливо корисні для рослин та як їх підтримати.

Як бактерії стимулюють зростання рослин?
Ґрунт — це набагато більше, ніж просто бруд, він живий. У чайній ложці грунту міститься більше бактерій, ніж людей землі. Один гектар родючого ґрунту може містити в середньому 8-15 тонн бактерій, грибів, найпростіших, нематод, дощових черв'яків та членистоногих.
Мудра природа подбала про рослини. Ґрунтові мікроби утворюють симбіотичні (взаємовигідні) відносини з рослинами, посилюючи захист від патогенів та стимулюючи їх зростання в обмін на джерела їжі. Такі мікроби є особливий клас бактерій, які займають ризосферу (кореневу зону) і мають здатність покращувати розвиток і підвищувати захисні сили рослин.
Як ми знаємо, рослини отримують їжу з ґрунту, в якому вони ростуть. Однак ця їжа доступна їм тільки завдяки великій різноманітності мікробів (особливо бактерій та грибків), які можуть хімічно та механічно перетворювати матеріали у ґрунті на поживні речовини. Таким чином, ці бактерії впливають на зростання рослин, полегшуючи доступ до таких поживних речовин, як азот, фосфор, залізо та інші.
Хоча азот, фосфор і залізо можуть бути удосталь у ґрунті, вони часто знаходяться у формі, яку рослина не може використовувати. Бактерії, що стимулюють зростання рослин, перетворюють ці поживні речовини на форму, яку рослина може легко використовувати для харчування.
Ці бактерії також можуть продукувати рослинні гормони, такі як ауксини, гібереліни та цитокініни. Ці гормони стимулюють зростання коренів і пагонів в обмін на джерела живлення, які вони отримують з рослини.
Крім того, бактерії, що стимулюють зростання рослин, мають здатність захищати рослини від патогенів. У боротьбі за поживні речовини вони витісняють патогени та виробляють антибіотики та протигрибкові метаболіти.
Подібні бактерії можуть допомогти рослині захистити себе від патогенів дуже дивним чином. Вони сприяють з того що у рослині запускається сигнал, який активує захисну систему. Це включає зміцнення клітинних стінок рослин, виробництво антимікробних речовин і синтез білків, пов'язаних з патогенами.

Ґрунтові мікроорганізми для підтримки здоров'я рослин
Триходерма (Trichoderma). Триходерма - це нитчасті гриби, що передаються через ґрунт. Ці гриби можуть колонізувати коріння рослин як зовні, і усередині. Вони постачають спеціалізовані білки, які змушують рослину підвищувати стійкість до хвороб, а також стимулюють фотосинтез у листі. Також триходерма виробляє та виділяє у ґрунт гормони росту рослин. Багато видів триходерми здатні продукувати ауксиновий фітогормон індол-3-оцтову кислоту, яка сприяє зростанню коріння. Триходерма широко використовуються в сільському господарстві як біофунгіцид. У основі механізмів біологічної боротьби у разі лежить мікопаразитизм, тобто вбивство одного гриба (патогенного) іншим.

Мікориза (Мycorrhiza). В екосистемах часто встановлюється симбіоз між корінням рослин та грибами. Структури, що утворюються внаслідок такого симбіозу, називаються мікоризою. У цьому випадку гриб живе всередині або зовні коріння рослини, і поживні речовини з ґрунту транспортуються до коренів через гіфи грибів. Гіфи (ниткоподібні утворення) можуть досліджувати більший обсяг ґрунту та досягати більш віддалених ділянок порівняно з корінням рослин. В результаті збільшується кількість поживних речовин, доступних рослинам, та покращується їх зростання. У свою чергу, рослини діляться із симбіотичними грибами своїми цукрами.
Лактобактерії (Lactobacillus). Лактобактерії - рід бактерій, які зазвичай зустрічаються в грунті та кишечнику людини і тварин. У науці відомі понад 200 видів лактобактерій. У ґрунті ці організми сприяють розкладанню органічної речовини. Крім розкладання органічних речовин, вони пригнічують хвороби рослин та надають регулюючу дію на зростання грибів, дріжджів та інших бактерій.
Сінна паличка (Bacillus subtilis). Близько 420 мільйонів років тому на суші почали розселятись рослини. У той час земля була в основному кам'янистою і ще не було ґрунту, який міг би допомогти рослинам рости. На щастя, мікроби вже були присутні на землі, і вони могли отримувати поживні речовини з гірських порід. Зокрема, бактерія Bacillus subtilis може виділяти марганець із гірських порід та переводити його у форму, яку легко засвоюють рослини. Багато штами Bacillus subtilis здатні діяти як агенти біоконтролю проти патогенних грибів і таким чином можуть використовуватися для придушення хвороб. Сінна паличка утворює біоплівки на коренях рослин і продукує більше 24 антибіотиків, посилюючи їхню антимікробну активність у ґрунті.



Пеніцилл (Penicillium). Грибки роду грибів-аскоміцетів. Пеніцилл впливає на зростання рослин, зумовлене продукцією та секрецією гіберелінів, які стимулюють зростання коренів. Крім того, види Pennicillium мають ефект індукованої систематичної стійкості на рослини за рахунок секреції ферментів, які викликають імунну відповідь рослин.
Дріжджі (Debarayomyces та Saccharomyces). Позитивний вплив на зростання рослин мають переважно два роди дріжджових грибків: Debarayomyces та Saccharomyces (Сахароміцети). Відомо, що представники обох цих пологів є організмами, що сприяють росту рослин. Дія дріжджів стимулює зростання рослин, зокрема, роблячи фосфати доступними для рослин, створюючи бар'єри для патогенних бактерій та грибків та виробляючи гормони росту рослин.
Корисні нематоди. Серед вчених часто жартують, що нематод можна зустріти всюди. Близько 90% дна океану та 80% Землі містять популяції нематод. У сімействі нематод є як корисні, і патогенні мікроорганізми. Корисні нематоди відіграють важливу роль у перетворенні поживних речовин грунту на форми, що легко засвоюються для рослин. Патогенні нематоди можуть руйнувати кореневу систему, викликати хвороби та негативно впливати на мікоризні гриби.
Інші види нематодів живляться бактеріями, грибами та/або іншими нематодами (залежно від виду). Ця битва розігрується у ґрунті під нашими ногами щодня. Збільшення кількості корисних нематод служить підкріпленням для рослин у ґрунті.

Як підтримати присутність корисних бактерій у ґрунті?
Мікроби потребують регулярних запасів активної органічної речовини, щоб вижити у ґрунті. Ґрунти, які не обробляли тривалий час, мають значно вищий рівень мікроорганізмів, більше активного вуглецю та органічної речовини, ніж ґрунти, що регулярно обробляються. Більшість мікробів у ґрунті існує в умовах голодування і тому схильні перебувати у стані спокою (особливо у розораних ґрунтах). Відмерлі рослинні залишки та поживні речовини для рослин стають їжею для мікробів у ґрунті.
Для оптимального зростання коріння рослин та мікроби потребують доступу деякої кількості повітря та води. На щастя, ґрунт повний мікросередовищ, що різняться за кількістю доступного повітря, води та поживних речовин. Ущільнення ґрунту та його порушення внаслідок обробки можуть зруйнувати це важливе мікросередовище, ускладнюючи проникнення коренів рослин у ґрунт, поглинання води та поживних речовин та взаємодію з корисними мікробами. Щоб звести до мінімуму ущільнення та забезпечити оптимальне середовище для вирощування, чітко розподіліть області для посадки та пересування по ділянці, наприклад, зробіть підняті грядки, розділені доріжками. Також розгляньте можливість використання ручних інструментів, щоб звести до мінімуму обробіток ґрунту, коли це можливо.



Верхні кілька сантиметрів грунту містять велику кількість мікроорганізмів, органічних і поживних речовин. Для захисту цінного верхнього шару ґрунту від ерозії можна використовувати мульчу або ґрунтопокривні культури, а також додавання органічної речовини в міру її розкладання.
Пестициди вбивають шкідників, але вони також можуть вбивати корисні ґрунтові мікроби та комах. Замість того, щоб шукати хімічний препарат, спробуйте спочатку розглянути біологічні альтернативи пестицидам. Вибирайте стійкі до хвороб сорти рослин та культури, які зможуть добре рости на ділянці. Більших шкідників зберіть вручну або збийте з рослин струменем із садового шланга і киньте в мильну воду.
Крім цього, існують спеціальні препарати на основі корисних для рослин грибків та штамів бактерій, які просто можна внести у ґрунт.
Коментарі (0):
Залишити коментар